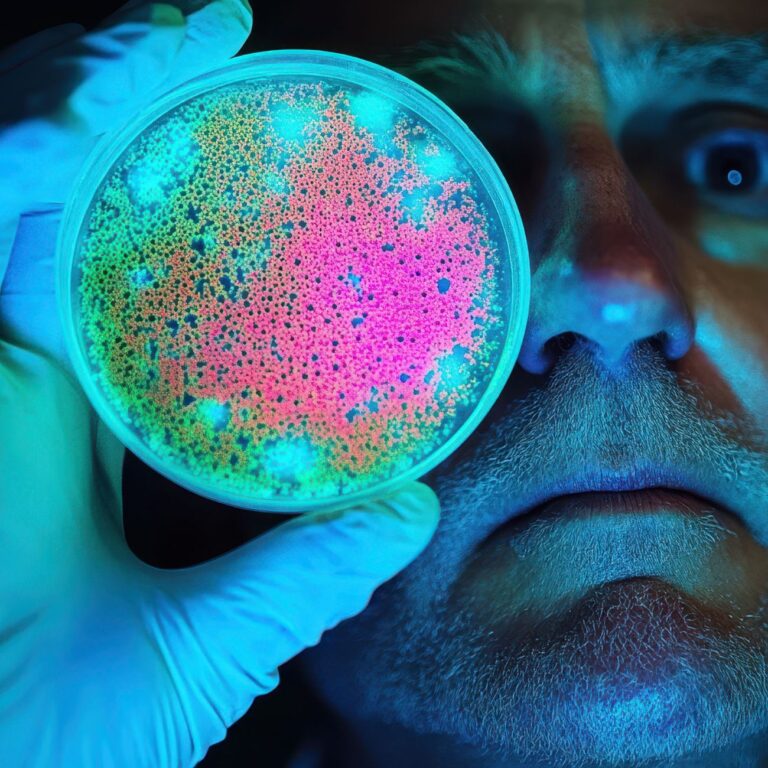

🔬 UVC-LED 살균 원리
UVC-LED 살균 원리는 better U 면도기 살균기의 핵심 기술이자, 우리 일상의 위생 습관을 바꿔주는 보이지 않는 빛의 과학입니다.우리가 매일 사용하는 면도기는 피부와 직접 닿는 도구이지만 습기와 온도에 노출되어 세균이 쉽게 번식합니다.그래서 better U는 그 문제를 근본적으로 해결하기 위해 275nm 파장의 UVC-LED를 적용했습니다.이 짧은 파장은 세균의 DNA를 직접 파괴하여 재생과 번식을 막는, 가장 확실한 살균 영역입니다….